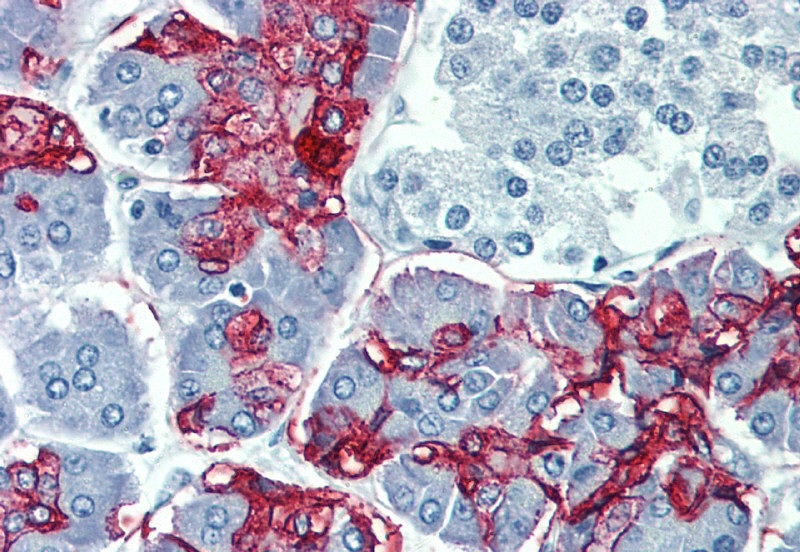
Blood Group Lewis a antibody [7LE]

相关产品推荐更多 >
万千商家帮你免费找货
0 人在求购买到急需产品
- 详细信息
- 文献和实验
- 技术资料
- 免疫原:
Mucin isolated by size-exclusion chromatography from an ovarian cyst fluid (pure endocervical type according to the Fenoglio´s classification).
- 亚型:
IgG1
- 形态:
Liquid
- 保存条件:
Store as concentrated solution. Centrifuge briefly prior to opening vial. Store at 4ºC. DO NOT FREEZE.
- 克隆性:
Monoclonal
- 标记物:
Unconjugated
- 适应物种:
Human
- 保质期:
12 months from the shipping date of the product.
- 抗原来源:
Human
- 目录编号:
GTX23967
- 级别:
Primary Antibodies
- 库存:
Available
- 供应商:
GeneTex
- 宿主:
Mouse
- 应用范围:
WB, IHC-P, ELISA
- 浓度:
1 mg/ml (Please refer to the vial label for the specific concentration.)
- 靶点:
Blood Group Lewis a
- 抗体英文名:
Blood Group Lewis a antibody [7LE]
- 抗体名:
Blood Group Lewis a 抗体 [7LE]
- 规格:
100 μg
IHC-P analysis of colorectal adenocarcinoma tissue using GTX23967 Blood Group Lewis a antibody [7LE].
IHC-P analysis of human pancreas tissue using GTX23967 Blood Group Lewis a antibody [7LE].
IHC-P analysis of human colon adenocarcinoma tissue using GTX23967 Blood Group Lewis a antibody [7LE].
风险提示:丁香通仅作为第三方平台,为商家信息发布提供平台空间。用户咨询产品时请注意保护个人信息及财产安全,合理判断,谨慎选购商品,商家和用户对交易行为负责。对于医疗器械类产品,请先查证核实企业经营资质和医疗器械产品注册证情况。
文献和实验血型 blood group 将不同个体的血液混合时,红细胞中的凝集原与另一个体血清中的凝集素发生作用,有时可出现凝集。由于凝集只在一定组合的条件下发生,因此接凝集的有无而将血液分为若干类型,这种类型称为血型。即属于同一血型者不凝集,如果发生凝集时则说明血型不同。在人类根据红细胞的抗原物质的特性,可分为 ABO血型或者 Rh血型等若干个类型。 ABO血型和 Rh血型在输血上有重要意义。对人类来说,最初就是根据 ABO血型而知道了凝集原与凝集素的关系,并阐明是通过复对立基
The Use of Maternal Plasma for Prenatal RhD Blood Group Genotyping
Alloimmunization to the blood group antibody anti-RhD (anti-D) is the most common cause of hemolytic disease of the fetus and newborn. Knowledge of fetal D type in women with anti-D makes management of the pregnancy much easier and avoids
Overview of Experimental Models of the Blood‐Brain Barrier in CNS Drug Discovery
. How do immune cells overcome the blood–brain barrier in multiple sclerosis? FEBS Lett. 585:3770‐3780. Le, S., Gruner, J.A., Mathiasen, J.R., Marino, M.J., and Schaffhauser, H. 2008
技术资料暂无技术资料 索取技术资料

![CD5 antibody [6A11]](https://img1.dxycdn.com/2022/0328/668/6985674327233500453-14.jpg!wh200)


![Pumilio 2 antibody [C2C3], C-term](https://img1.dxycdn.com/2022/0328/222/4840782886820300453-14.jpg!wh200)


